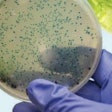
Contamination testing and adherence to third-party standards play a significant role in sanitation compliance.

Business Intelligence
Page 1 of 25
Next PageList: Digitalization Companies From PACK EXPO
Looking for CPG-focused digital transformation solutions? Download our editor-curated list from PACK EXPO featuring top companies offering warehouse management, ERP, digital twin, and MES software with supply chain visibility and analytics capabilities—all tailored specifically for CPG operations.
Download Now
Downloads